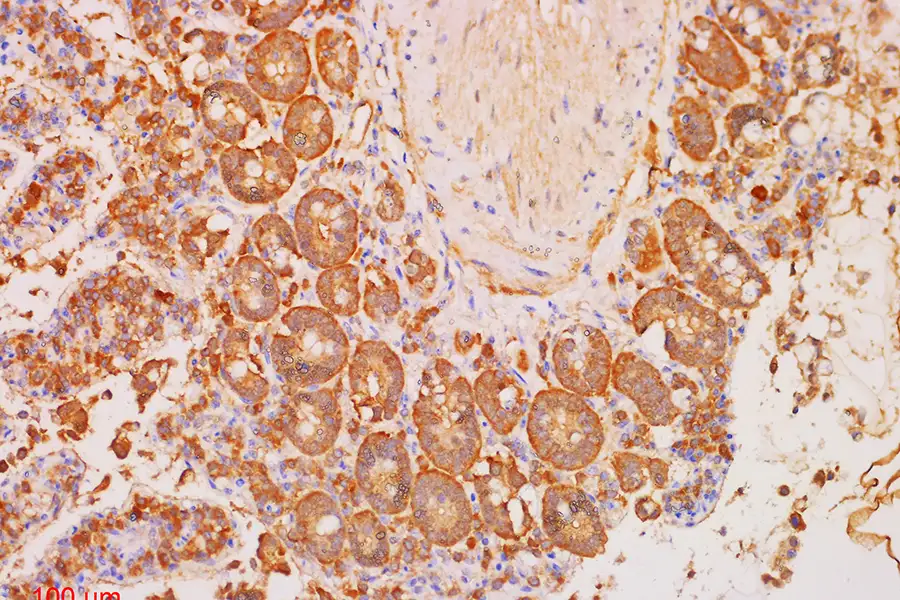
drying tissue samples

As a laboratory manager, you know how power cuts or cold storage failures can compromise your operations and years of research. To mitigate that risk, you may want to add or upgrade the lyophilisation or freeze-drying process for biological samples at your facility.
But are you familiar with which processes can use freeze-dried samples? If not, here’s a review of where lyophilisation is appropriate and which freeze-dryer model works best for that purpose.
Quick Review: A Typical Storage ‘Cold Chain’ (Without Freeze-Dryers)
In the refrigeration tech industry, the “cold chain” refers to a series of steps that provide temperature-controlled preservation and storage of products. The goal of this chain is to prevent samples from degrading or becoming too chemically or structurally altered to remain useful.
Prevention Targets: 3 Key Degradation Pathways

Because most biological materials are thermally unstable, the cold chain specifically targets:
- Enzymatic Activity: In many samples, heat acts like a “start” button for enzymes that begin to eat away at DNA or proteins. Cold temperatures keep these enzymes “asleep.”
- Microbial Growth: Warmth allows bacteria to multiply. In a clinical sample, even a small amount of bacterial growth can lead to a misdiagnosis.
- Irreversible Molecular Damage: For test products like new mRNA vaccines, once the molecular structure “unfolds” due to heat, it cannot be “re-folded” by putting it back in the freezer. The damage is permanent.
The 4 Links in the ‘Cold Chain’
When applied to biological sample preservation (e.g., for medical research), that “cold chain” spans from the moment a sample is collected to the moment it is used.

- Manufacturing & Storage: The race to preserve a biological sample in the best way possible starts upon its creation. Whether in a lab or a factory, every sample is immediately placed in specialised storage units (e.g., laboratory freezers) to stabilise its molecular structure.
- Transportation: If samples are destined for a location far from the original place they were collected, a form of refrigerated transport is required. Depending on the circumstances, that can be anything from a portable cold box to refrigerated trucks and insulated “dry shippers” (using liquid nitrogen or dry ice). This is often the riskiest link because of temperature excursions during loading and unloading.
- Local Distribution: Once samples arrive at a clinic, hospital or research hub, these must be quickly transferred to a local cold storage unit (e.g., laboratory refrigerators). These act as the “holding bay” before use.
- Administration: The final step. The researcher or clinician removes a sample from the cold environment moments before it is analysed or injected.
Cold Chain Examples
| Type of Chain | Temperature Range | Common Uses |
| Refrigerated | 2º to 8º C | Attenuated viruses, insulin, and many reagents |
| Frozen | -15º to -25º C | Enzymes, certain biologics, and plasma |
| Deep Frozen | -70º to -80º C (Ultra-Low Temperature or UHT) | mRNA vaccine, long-term tissue storage, and viral vectors |
| Cryogenic | Typically below -150º C (sometimes reaching -196º C); commonly using liquid nitrogen |
Stem cells, cord blood, and reproductive materials |
Successful sample preservation depends heavily on the cold storage technology employed throughout the cold chain. Thus, refrigerators and freezers designed for specific temperature range requirements are a must.
Freeze-Drying Biological Samples
Unfortunately, refrigerated or frozen samples are still vulnerable to power outages or mechanical failures. Such events could expose them to heat or rapid drops in temperature that encourage either decomposition or excess ice crystal formation.
One alternative is dehydration. The reduction of water content in a sample slows down degradation and microbial growth. However, dehydration is also often heat-based, which could partly compromise a sample’s integrity.
Here’s where freeze-drying can be a possible ‘middle ground’ solution.
The Advantages of Freeze-Drying

Lyophilisation or freeze-drying is a more sophisticated dehydration process. It involves freezing a sample and then reducing the surrounding pressure. That allows the sample’s frozen water content to sublimate directly from the solid to the gas phase.
- No liquid phase – greatly slows many heat- and water-driven reactions; less heat damage and fewer chemical reactions
- Very low moisture – long-term stability without refrigeration
However, lyophilisation is not a universal substitute for the cold storage sample preservation method. Its suitability depends heavily on what you want to measure and how the sample will be used. In well-designed protocols, freeze-drying can preserve key analytical qualities — but only if the downstream application is compatible with the changes it introduces.
Where Freeze-Drying May Be Applicable
1. Preserving select molecules rather than living systems

If your goal is to preserve certain molecules rather than the complete structure of tissues, freeze-drying may be appropriate.
Molecules such as proteins and RNA can remain stable for months in lyophilised tissue samples (when properly formulated and stored under controlled conditions), sometimes with comparable or even improved analytical reproducibility.
Common applications: Molecular biology (PCR, sequencing), proteomics, biochemical assays
2. Testing standards allow or require sample stabilisation

In certain research or testing contexts, samples could be better off (especially in terms of sample homogeneity) if they were freeze-dried. Some tests may even require samples that are powdered and/or reconstituted after lyophilisation.
Common applications:
- Tissue metabolomics and amino acid analysis
- DNA/RNA extraction from solid samples (e.g., plant samples)
- Forensic toxicology (e.g., post-mortem drug analysis of solid tissues)
- Nutritional analysis and food science (e.g., measuring micronutrients in food)
- Pharmaceutical and biomarker assays (e.g., tissue drug concentration studies)
- Soil microbiome and environmental pollutant studies
3. Creating long-term storage without a sufficient cold chain
An extra reason for resorting to freeze-drying is when your operations have severely limited resources and budget. This is especially true for scenarios where there’s a high probability for breaks in the cold chain and “freeze-thaw-refreezing” events.

- Useful when −80 °C freezers or liquid nitrogen aren’t practical (e.g. fieldwork, transport)
- Once freeze-dried, some samples still need some refrigeration in storage, often at 4 °C
- Some formulations even allow storage at 15–25 °C when they are sealed against moisture and oxygen
Common applications: biobanking, transport of specific archaeological or paleontological samples from remote sites, global research collaborations
Preferred Preservation Methods (per Example Application)
| Example Goal | Preferred / Appropriate Method |
|---|---|
| Preserve live cells / tissues for future dissection | Cryopreservation (typically ≤ −150 °C, commonly through liquid nitrogen) |
| Maintain morphology (histology) | Fixation (e.g. formalin) |
| Preserve DNA/RNA/proteins for analysis | ✅ Lyophilisation or freezing |
| Enable transport without cold chain | ✅ Lyophilisation |
| Maximise enzymatic activity retention | Case-by-case |
Freeze-Drying As An Additional Method to Cold Storage Preservation
Lyophilisation or freeze-drying is sometimes combined with the usual refrigeration or freezing method. Below are a few examples.
Case 1: Protein-based biologics
Example: Cytokine proteins like Interferons (alpha, beta, gamma) for the treatment of some cancers, multiple sclerosis, and rare immune disorders
General preservation process:
- Freeze-dry Interferon samples during extraction/manufacture
- Refrigerate freeze-dried samples
- Reconstitute before injection (testing)
Case 2: Enzyme research and biochemical assays
Example: Alkaline phosphatase enzyme activity assays
General preservation process:
- Obtain purified enzyme (often from bacterial or mammalian expression systems)
- Freeze-dry and turn into powder
- Store freeze-dried sample refrigerated or frozen
- Rehydrate before testing (i.e., electrophoresis/SDS-PAGE)
Case 3: Niche histophathology
Example: Intracellular protein localisation studies that require freezing/cryofreezing (instead of formalin fixation and paraffin embedding)
General preservation process:
- Rapid freezing of fresh tissue (often with the help of liquid nitrogen)
- Cryosectioning – thin sections are cut using a cryostat
- Lyophilisation of sections
- Storage at low temperature (refrigerated or frozen)
- Rehydration and staining for testing (immunohistochemistry)
Where Freeze-Drying is NOT Suitable
Lyophilisation is not suitable for some applications, as the process can alter some characteristics of samples and interfere with downstream analyses. Especially when:

- You’re trying to preserve live/viable cells, fine tissue structures, and some enzymes
- Your testing standards cannot tolerate structural or chemical alterations (e.g., an imperfect reconstitution of a freeze-dried sample; some protein denaturing)
Examples of unsuitable applications:
- histology (tissue architecture)
- certain metabolomics workflows (volatile compounds may be lost)
- microbiological viability studies
- sensitive protein studies
Different Techniques, Different Freeze-Drying Units
Lyophilisation or freeze-drying is basically a “freeze-dry-vacuum” cycle. However, it is not a one-size-fits-all process.
If lyophilisation or freeze-drying is indeed applicable in your work, you need to know which type of freeze-dryer model is appropriate. That depends on your sample type, the stability of the solute, required batch volumes, storage goals, and the intended sample end-use.
1. Manifold Lyophilisation

This is the most common technique for small-scale research labs. Samples are typically frozen in flasks, which are then attached to a manifold or “tree.”
- Best For: High-volume, low-diversity samples where individual temperature control for each vial isn’t a priority.
- Ideal Unit: Benchtop Freeze-Dryers. For labs with limited footprint, these compact units offer the necessary manifold attachments to handle multiple small batches of peptides or reagents simultaneously.
2. Batch Processing or Tray/Chamber Freeze-Drying)
This technique is best for larger-sized samples. These are placed on a tray, which is inserted into a freeze dryer’s sealed chamber.

- Best For: Larger-scale diagnostic production or small pharmaceutical manufacturing (for testing).
- Ideal Unit: Standing Laboratory / Pilot Production Freeze-Dryers (3kg to 20kg capacity) are built for this. These units allow for “stoppering” under vacuum, ensuring that vials are sealed before they are exposed to oxygen, which is a critical requirement for maintaining sterility in clinical settings. Yet these freeze-dryers won’t occupy an enormous footprint in a laboratory.
3. Bulk Freeze-Drying

For bulk productions or large-sized samples, these are poured or placed directly onto multiple trays.
- Best For: Non-vialed materials such as nutritional supplements, sensitive forensic and archaeological evidence, soil samples, or raw biological feedstock.
- Ideal Unit: Large Production Scale Freeze-Dryers (up to 2,500kg) are the workhorses for bulk processing. They feature heavy-duty stainless steel construction designed for easy cleaning and high-throughput repeatability.
Summary: How A Freeze-Dryer Works
A laboratory lyophiliser or freeze-dryer is not just a cooling chamber. It is a precision instrument that efficiently manages three distinct phases in lyophilisation.
Phase 1: The Freezing (Thermal Treatment)
If a sample is frozen too slowly, large ice crystals form, which can puncture cell membranes.
- Annealing: Some researchers utilise “annealing”—cycling the temperature up and down during the freeze stage. Freeze-dryer units feature programmable logic controllers (PLCs) that allow for precise temperature ramp-and-soak cycles, enabling automated annealing protocols.
Phase 2: Primary Drying (Sublimation)

Here, the vacuum is introduced. This stage removes roughly 95% of the water. If the vacuum is too strong or the heat too low, the process takes forever. Freeze-dryers utilise high-efficiency vacuum pumps and precise shelf heating to find the optimal operating range.
Phase 3: Secondary Drying (Desorption)
Even after the ice is gone, “bound” water molecules remain. Secondary drying uses higher temperatures and lower vacuum levels to “pull” those final molecules away. (Achieving residual moisture levels typically in the 1–3% range is common for many pharmaceutical formulations.)
Frequently Asked Questions (FAQs)
Q: Can I use one freeze-dryer for both proteins and forensic samples?
A: Generally, yes, provided the unit is thoroughly decontaminated between runs. However, for high-sensitivity genomic work, many labs prefer a dedicated benchtop freeze-dryer unit to eliminate any risk of cross-contamination.
Q: Can I freeze-dry samples containing alcohols or acids?
A: Only if you use a freeze-dryer equipped with a condenser that can reach at least -80º C. Freeze-dryers with condensers capable of very low temperatures (e.g. −80 °C) can prevent solvent vapours from reaching the vacuum pump. For these more extreme applications, low-temperature freeze-dryers are a mechanical necessity.

Q: How long does a typical freeze-drying cycle take?
A: This depends entirely on the sample thickness and the “eutectic point” of the material. A standard run can last anywhere from 24 to 72 hours. Lyophilisers like the standing laboratory/pilot production freeze-dryer help shorten this time by providing more precise shelf heating.
Q: Does freeze-drying affect the potency of live-attenuated viruses?
A: Lyophilisation is widely used to stabilise many viruses and vaccines, allowing storage over long periods. When done correctly using a “protective” medium (like sucrose or trehalose), it is far more stable than suspending attenuated virus samples in liquid.
Q: Are there instances in archaeology or forensics that may require freeze-drying of samples for preservation?
A: If you are dealing with a limited-evidence source that’s in danger of rotting away even when undisturbed (in situ), e.g., wood from shipwrecks, then freeze-drying samples may be necessary.
In some cases—such as fragile wood fragments from muddy or waterlogged archaeological sites—items may need to be soaked in polyethylene glycol (PEG) first before being freeze-dried. If these are small enough, they can be handled by standard laboratory lyophiliser models. (Note: This is only for the preservation of samples for scientific analyses and not entire artifacts.)
Q: Is it better to buy a larger unit than I currently need?
A: We often suggest “scaling for the future.” If your research might grow from test tubes to 500ml flasks, moving from a benchtop model to a standing laboratory freeze-dryer now can save you the cost of a full equipment replacement in a few years.
Protect the integrity of your research now

If you’re considering adding the best freeze-dryers in Australia to your laboratory or production workflow, it pays to speak with engineers who understand both the science and the equipment behind the process.
At Flo-Max Pumps, we work closely with managers of research laboratories and diagnostic facilities to customise freeze-drying systems for specific applications, from compact clinic benchtop units to large-scale processing equipment.
Moreover, we also offer laboratory refrigerators and freezers to help you expand to a full range of preservation and storage options.
Let’s combine your research management expertise with our freeze-dryer engineering. Talk to our engineering team today to discuss your sample preservation requirements and explore the right solutions for your operations.












